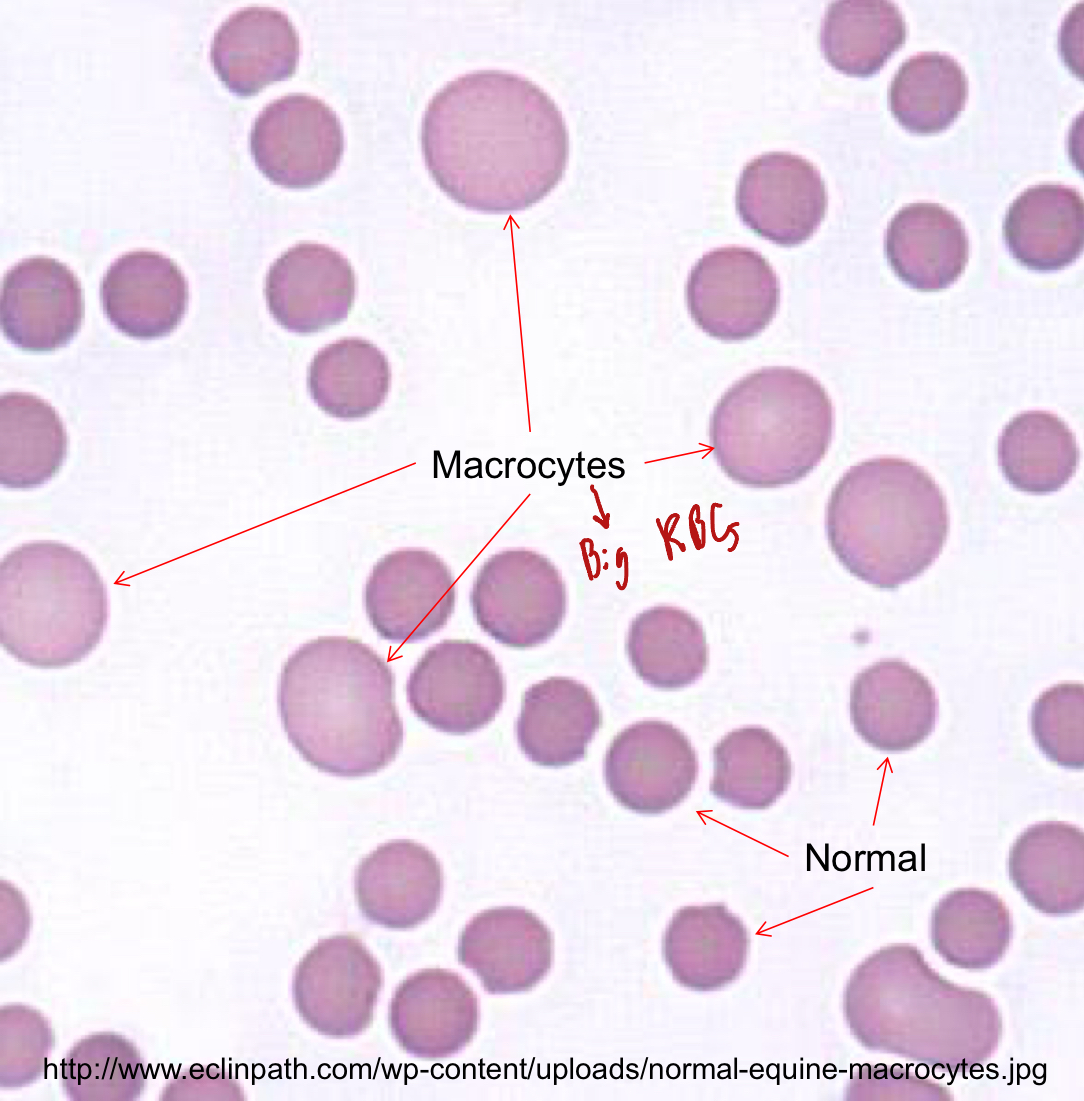
<ol><li><p>Accelerated erythropoiesis</p><ol><li><p>Young RBCs are larger than mature ones, therefore, the accelerated production of erythrocytes can cause an <u>inc in the MCV</u></p></li></ol></li><li><p>FeLV</p><ol><li><p>FeLV can cause <span style="color: red;">non-regenerative anemia</span> in cats</p></li><li><p>The bone marrow isn’t producing enough RBCs to replace the lost ones, this high inc in young RBCs leads to an increase of MCV</p></li></ol></li></ol><p></p>
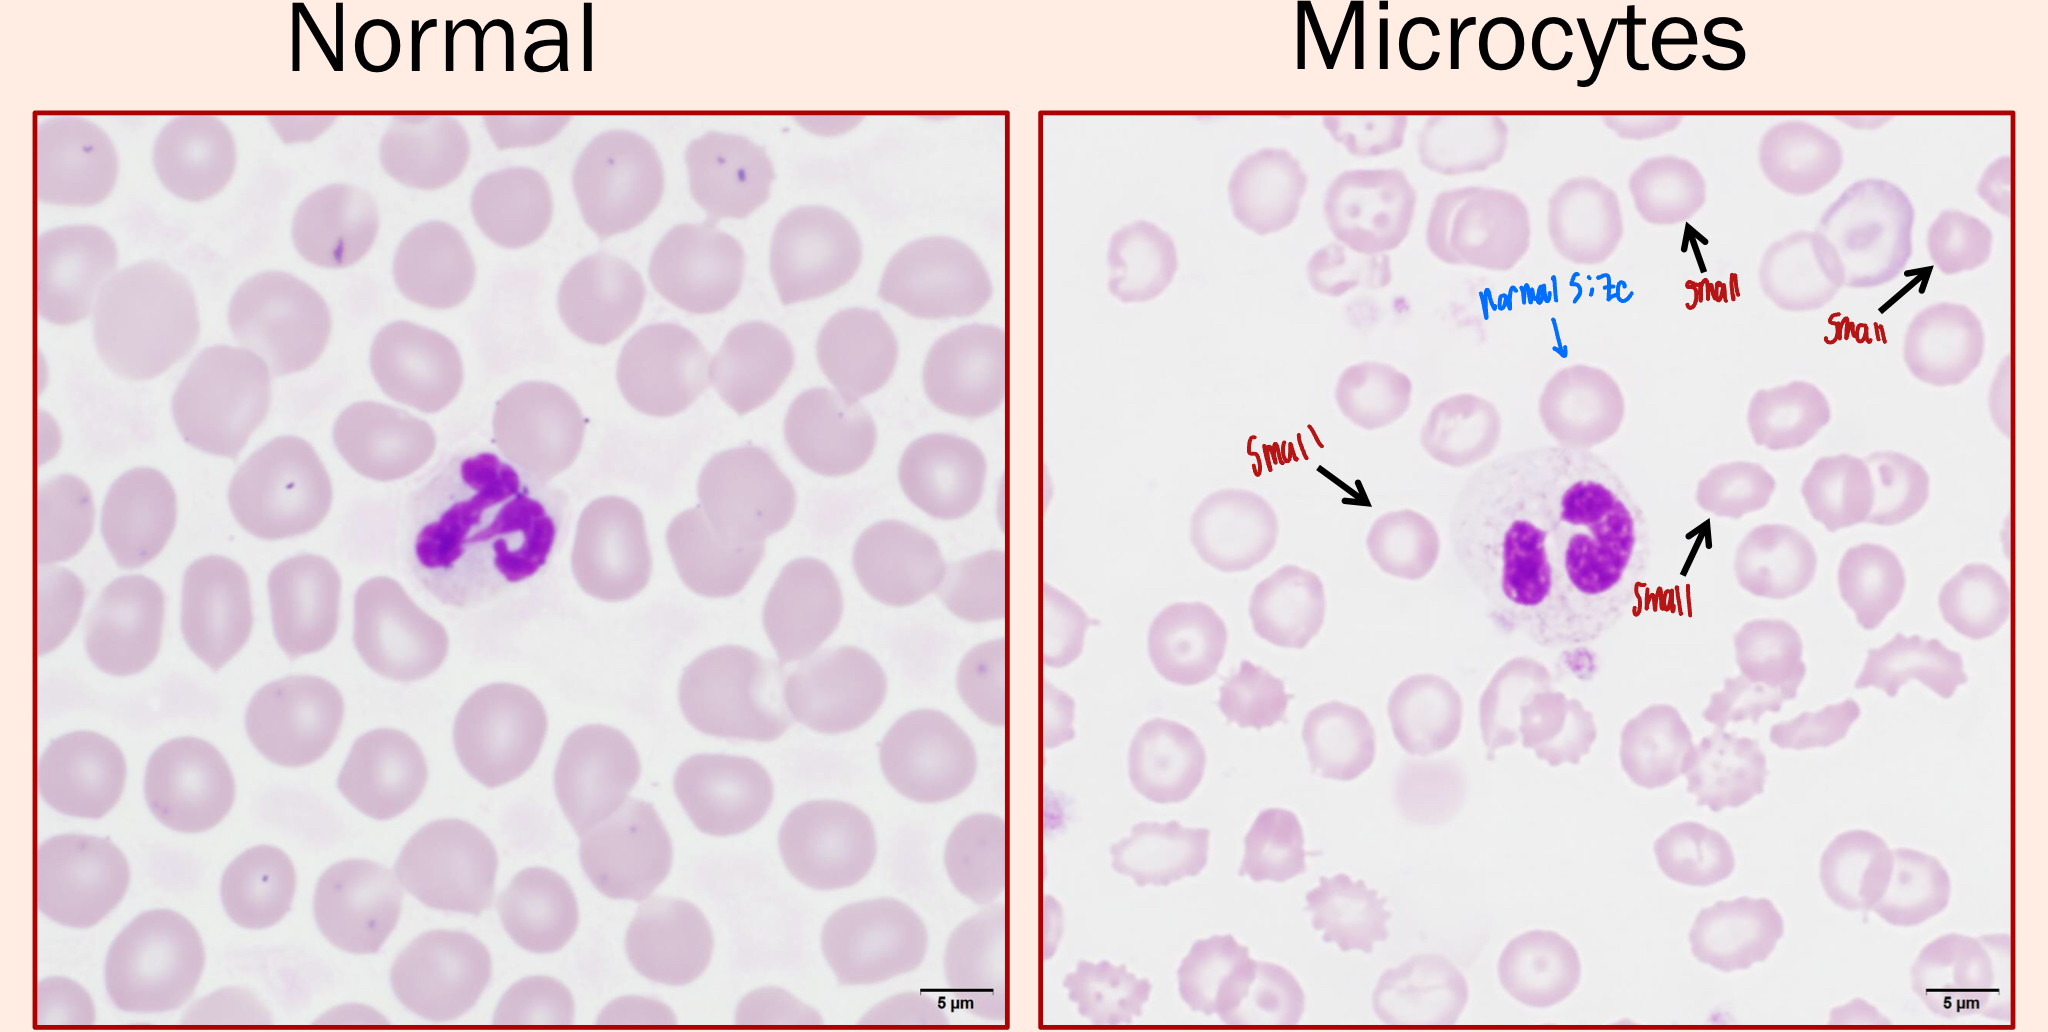
<ol><li><p><strong><u>Iron deficiency anemia</u></strong></p><ol><li><p>The lack of Iron causes anemia, but it also causes microcytes</p></li><li><p>Without the iron, the RBCs don’t develop to full size</p></li></ol></li><li><p>Hepatic Insufficiency</p><ol><li><p>How?? I don’t know </p></li></ol></li><li><p>Breed Predispositions</p><ol><li><p>Asian Breed Dogs</p></li><li><p>Akita, Shar-peis, Jindos</p></li></ol></li><li><p>Young Animals</p></li></ol><p></p>
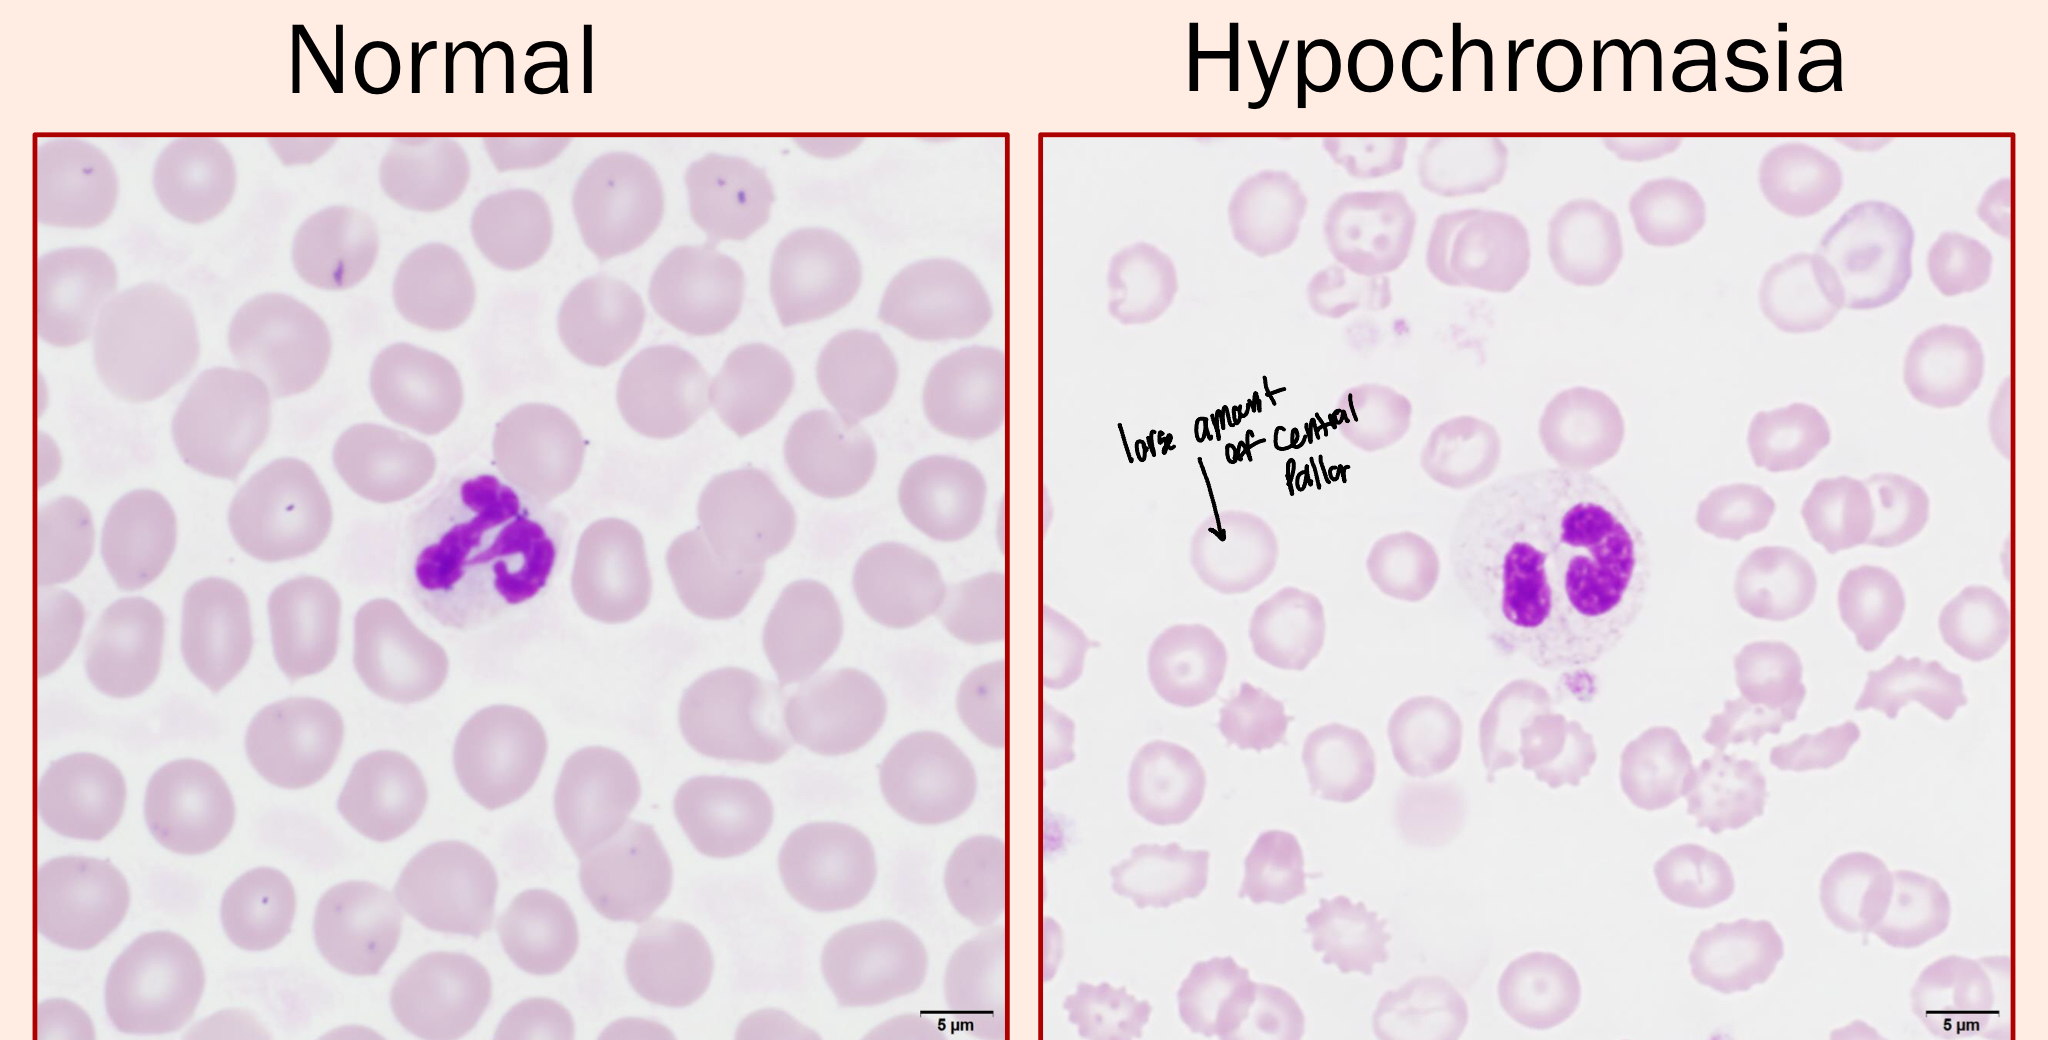
<ul><li><p>RBCs with increased central pallor (whiter/clearer in the middle)</p></li><li><p>Hypochromic Erythrocytes have a decreased Hgb</p></li><li><p>They indicate a decreased MCHC</p></li></ul><p></p>
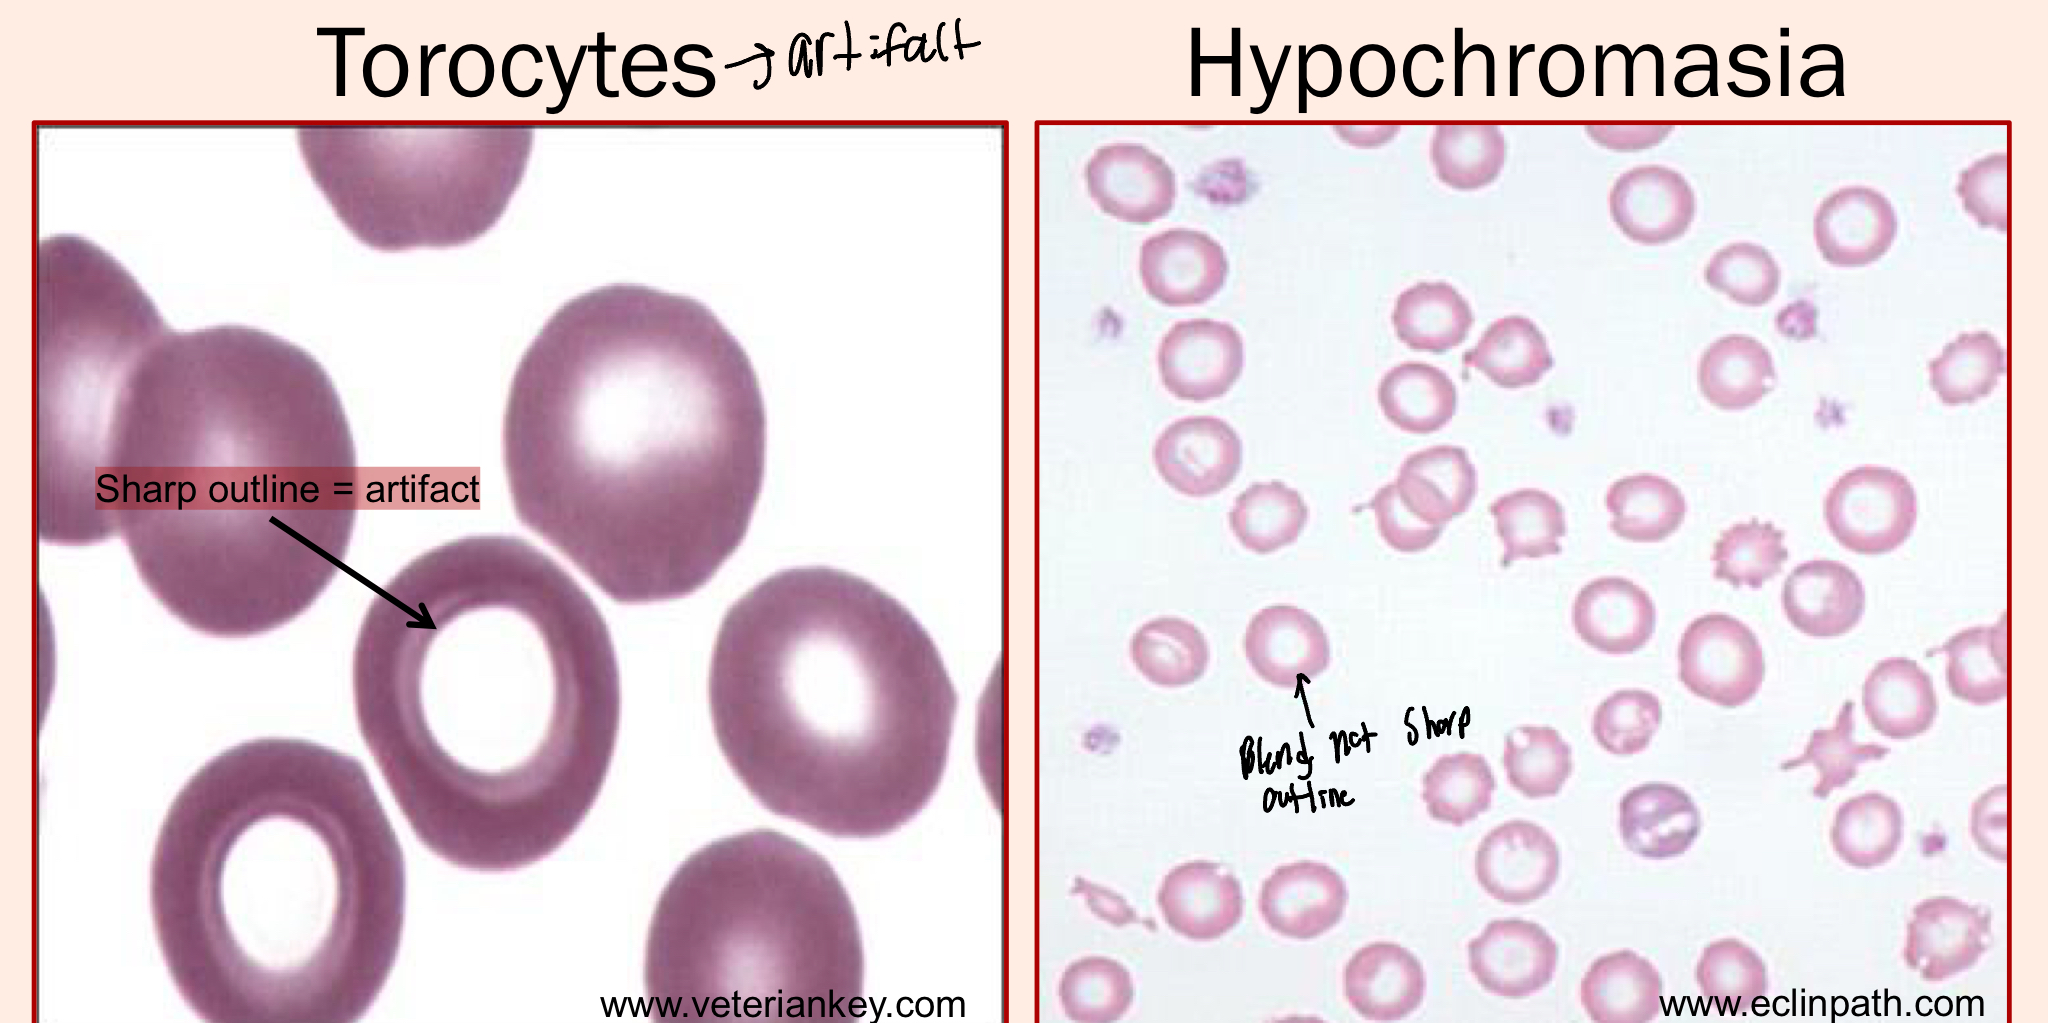
knowt flashcard image
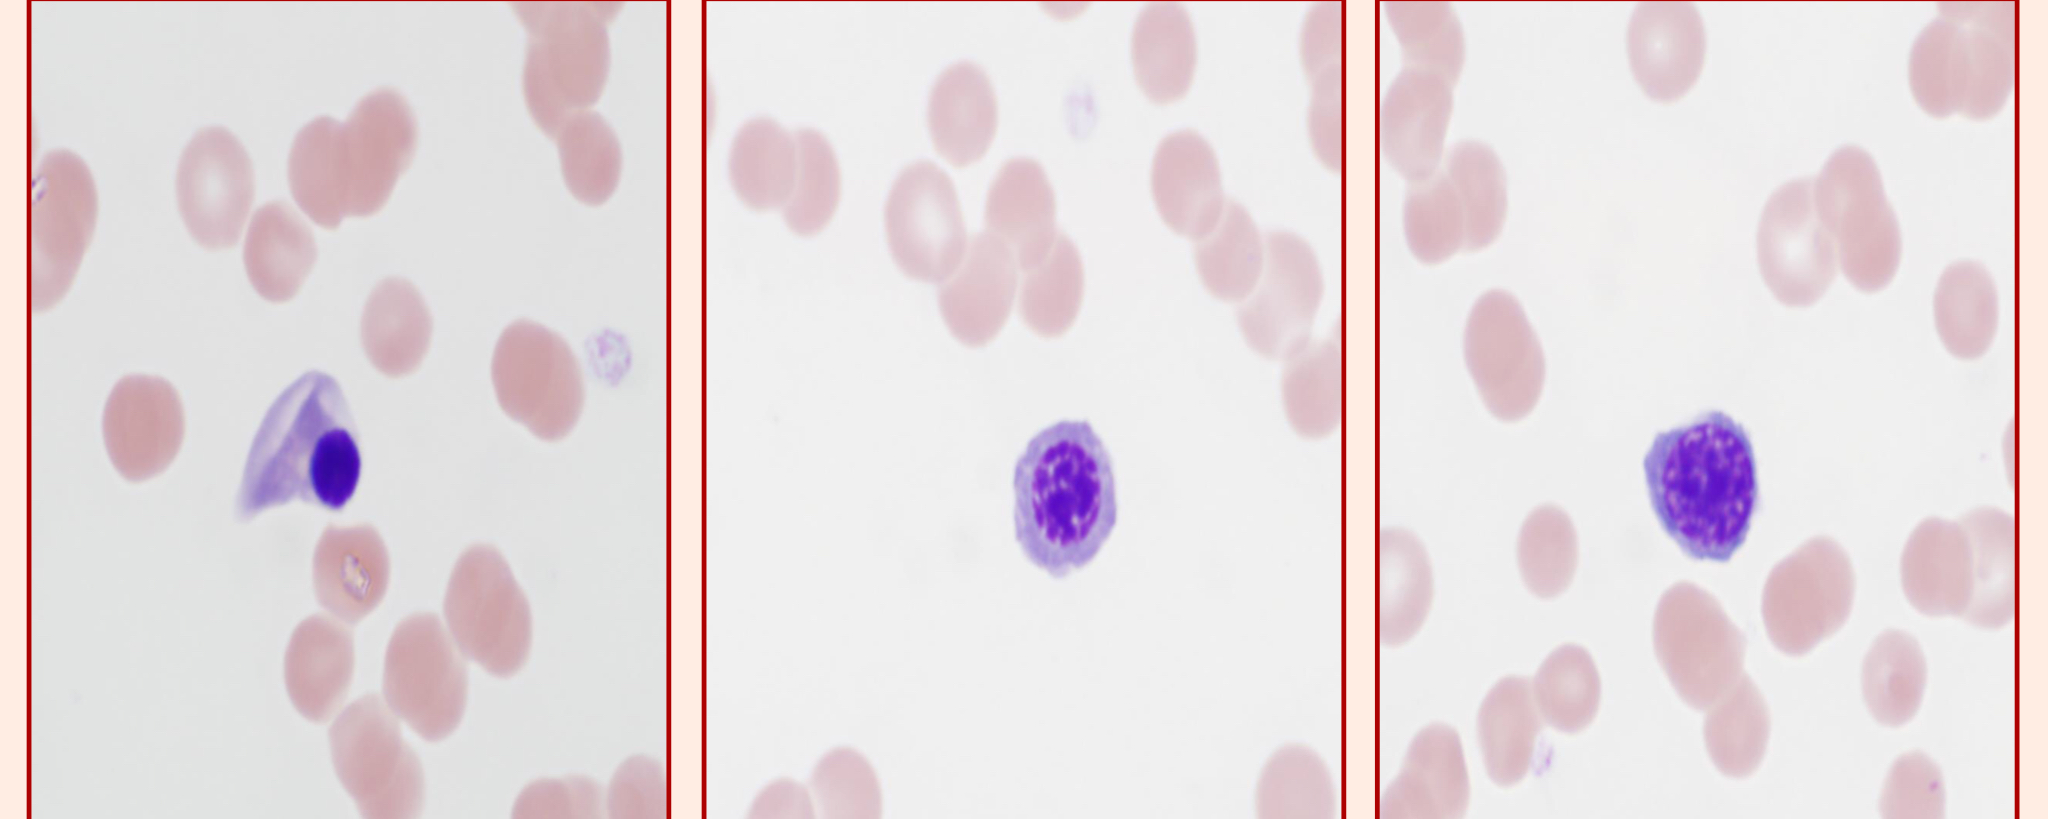
<p>Nucleated RBCs, they are immature RBCs</p>

1/47
Looks like no tags are added yet.
Name | Mastery | Learn | Test | Matching | Spaced | Call with Kai |
|---|
No analytics yet
Send a link to your students to track their progress
What are the 7 components of an Erythrogram?
Erythrocyte Concentration
Hemoglobin Concentration
Hematocrit
Erythrocyte (Wintrobes) Indicies
Polychromasia/Reticulocytes
Nucleated Erythrocytes
Erythrocyte morphology/Inclusions/Infectious Agents
What is the difference between an Erythron and an Erythrogram?
Erythron
This is all the erythroid cells (including precursors)
Erythrogram
Analytic methods used to evaluate the Erythron
Erythrogram evaluates the Erythron
Define this part of the Eyrthrogram
Erythrocyte Concentration
It is the # of RBCs per unit of volume of blood (aka the RBC count)
Is the âErythrocyte concentrationâ a measured or calculated value?
Measured

The Erythrocyte Concentration accurately reflects the Hematocrit and the Hemoglobin concentration if the ___ and _____ are within reference limits
MCV (Mean Corpuscular Volume) and MCHC (Mean Corpuscular Hemoglobin Concentration)
Define this part of the Eyrthrogram
Hemoglobin Concentration
The grams of Hemoglobin (Hgb) per 100ml of blood
Is the âhemoglobin concentrationâ a measured or calculated value?
Measured

The hemoglobin concentration is a good reflection of the bloodâs _____________ capacity
O2 Carrying capacity
What is unique about the measurement of Hgb?
Hgb is present with the Erythrocytes, so they have to be lysed in order to measure the Hgb
Define this part of the Eyrthrogram
Hematocrit (HCT)
The percentage of blood volume filled by erythrocytes
Ex: in 100 mls of blood, if the HCT is 0.45 L/L then erythrocytes occupy 45ml

Is Hematocrit a measured or calculated value?
Calculated (Hct = MCV * RBC)
What are the 3 Erythrocyte Indicies?
Mean Cell Volume (MCV)
Mean Cell Hemoglobin
Mean Cell Hemoglobin Concentration (MCHC)
Which Erythrocyte Indicie is not commonly used, why?
Mean Cell Hemoglobin (MCH)
It is very similar to MCHC and âweâ prefer MCHC
What is the Mean Cell Volume (MCV)? Is it measured or calculated?
It is the volume per average RBC
Essentially, it detects the variation in size/volume of RBCs
Mesured

What is the Mean Corpuscular Hemoglobin Concentration (MCHC)? Is it measured or calculated?
It is the cellular Hgb per average RBC
This also anylyzes the average ability of a cell to carry oxygen
Calculated
Hgb/HCT
What is Anisocytosis?
A condition where there is a significant variation in the size of red blood cells (RBCs)
This can be a variation in size or volume
Caused by Macrocytosis or microcytosis
What is the difference between Macrocyte and Macrocytosis?
A macrocyte is an erythrocyte with an increased volume
Macrocytosis is an increased concentration of Macrocytes
What is the RDW?
Red Cell Distribution Width
It is the standard deviation of the MCV

What would cause an increase in the RDW (Red Cell Distribution Width)?
An increase of Macrocytes/Microcytes
What would cause an increase in the MCV (Mean Corpuscular Volume)?
Presence of Macrocytes if normal erythrocytes/microcytes are also present
âRBCs are larger than normalâ
An increase of MCV is aka?
Macrocytosis
What are 2 conditions that can cause an Increased MCV?
Accelerated erythropoiesis
Young RBCs are larger than mature ones, therefore, the accelerated production of erythrocytes can cause an inc in the MCV
FeLV
FeLV can cause non-regenerative anemia in cats
The bone marrow isnât producing enough RBCs to replace the lost ones, this high inc in young RBCs leads to an increase of MCV
T/F: An increased RDW (Red Cell Distribution Width) is associtated with only Macrocytosis
False, both Macro/Micro-cytosis
Can microcytes be an incidental finding? Why or why not?
Yes, some solutions such as EDTA are hypertonic and can cause the RBCs to appear smaller, this is known as a cell shrinkage artifact
What are some causes of Decreased MCV?
Iron deficiency anemia
The lack of Iron causes anemia, but it also causes microcytes
Without the iron, the RBCs donât develop to full size
Hepatic Insufficiency
How?? I donât know
Breed Predispositions
Asian Breed Dogs
Akita, Shar-peis, Jindos
Young Animals
What are Hypochromic erythrocytes? What types of Erythrogram disturbance do they indicate?
RBCs with increased central pallor (whiter/clearer in the middle)
Hypochromic Erythrocytes have a decreased Hgb
They indicate a decreased MCHC
What are some causes of a decreased MCHC?
Regenerative response to anemia
In an effort to respond to anemia the body rapidly produces more RBCs, these RBCs are large and immature and have less Hgb
Essentially, there is more volume (large immature RBCs) and less Hgb â Decreased MCHC
Iron deficiency
If a decrease in MCHC is detected without microscopic evidence of hypochromasia, what is the typical cause?
Artificial cell swelling
What is the difference between a torocyte and hypochromasia?
T/F: Increased MCHC is cause for a concern
False, it is normally an artifact
What is the most common cause of increased MCV in cats?
Non-regenerative Anemia caused by FeLV
What are sources of falsely increased MCHC?
Cell shrinkage artifact
In-vitro hemolysis
Spectral interferences with Hgb assay
Lipemic samples
Heinz bodies
Is MCHC measured or calculated?
Calculated (MCHC=Hgb/Hct)
MCHC is the mean of the concentration of hemoglobin contained within the space of the erythrocytes
MCHC will increase when Hgb ___ and HCT ___
Hemoglobin Increases
Hematocrit Decreases
MCHC = (Hgb/HCT)
What are Reticulocytes/Polychromatophils? What is the difference between the two?
Anucleate, Immature erythrocytes with stainable cytoplasmic RNA
The difference is in the staining
Wright-Giemsa stain = Polychromatophils
New Methylene Blue = Reticulocytes

What is the lifespan of reticulocytes in Dogs vs in cats?
Dogs
1-2 days
Cats
Variable (lifespan and type)
What are the 2 different types of cat reticulocytes? Which ones do we count?
Aggregate
We count these ones
Larger cells with aggregates of reticulum
Punctate
Smaller granules, 2-6 reticulum
They look like individual flakes of pepper or individual circles

What is Reticulocytosis?
An increased Reticulocyte count
What is Reticulocytosis good evidence of?
Increased Erythropoiesis
The two different types of Reticulocytes in cats can help us get an idea the timeline of erythropoiesis the animal is in. Describe the different stages
Aggregate
3-5 days post anemic event
Punctate
7-14 days post anemic event
The degree of increased polychromasia should correspond to the degree of ____________ in dogs and cattle, and to _______ ________ in cats
Reticulocytosis
Aggregate Reticulocytosis
How do you know that an animal has reticulocytosis?
By calculating the Reticulocyte Percentage (RP)
and then using the RP to calculate the reticulocyte count
RC = RP * RBC
The Reticulocyte count is then used to estimate if the patient is in a regenerative or non-regenerative anemia
T/F: An increase in Reticulocyte Percentage means that the animal is in Reticulocytosis
False, RP=(Reticulocytes/RBCS), so a decrease in RBCs may make the RP appear larger, the best way to determine a regenerative vs non-regenerative anemia is to use the Reticulocyte count

What are nRBCs?
Nucleated RBCs, they are immature RBCs
T/F: We can use machines to calculate nRBC
False, they will often misclassify the nRBCs, so it is best to do it by hand

What is Rubricytosis? What is it associated with?
An increased # of nRBCs
Regenerative anemias

**T/F: If a Rubricytosis is present then the animal has a regenerative anemia**
False, while it is commonly seen along with regenerative anemais, it is not ALWAYS there
Inappropriate Rubricytosis (Rubricytosis associated w. non-regenerative anemias) is caused by what?
Loss of the finely controlled release of RBCs
Marrow damage
Splenectomy
Splenic contraction
Lead toxicosis